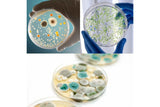
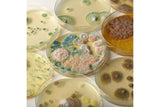
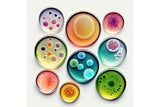

Heebie Jeebies Revolting Science Experiment Gross Stomach Kids STEM Toy Kit 8+
Term:
100% Traditional Layby. Delivery after full payment.
Attention, eager beaver! Need your delivery in a flash?
No worries, mate! We're here to save the day! Just give us an email at contact@layawayau.com and let us know if you would like to pay more or less each week. Rest assured, we'll also provide you with an estimated delivery date when we make these changes. So don't you worry, your delivery dreams are in safe hands!
Product Details
Heebie Jeebies Revolting Science Experiment Kids STEM Toy Kit 8+
Revolting Science is a gross science kit that allows kids to explore the fascinating world of bacteria with hands-on experiments. Featuring easy-to-follow instructions and high-quality materials, it is an ideal tool to introduce kids to microbial science in a fun and interactive way.
Specifications
Warranty & Returns
This product is sold by a third-party seller and they are responsible for their product, the content of their listing and any exchanges of return of their product.
All products sold by third-parties are subject to the Customer Charter and comes with guarantees that cannot be excluded under the Australian Consumer Law.
We can only process ONE order per customer at a time.
Term:
Recently viewed
So..... Why Layaway AU?
Layaway AU has had over 18,000+ applications in Queensland alone. Not only is Layaway AU well known and trusted in communities around Australia but Layaway AU offers many amazing benefits such as, No late fees, no management fees.